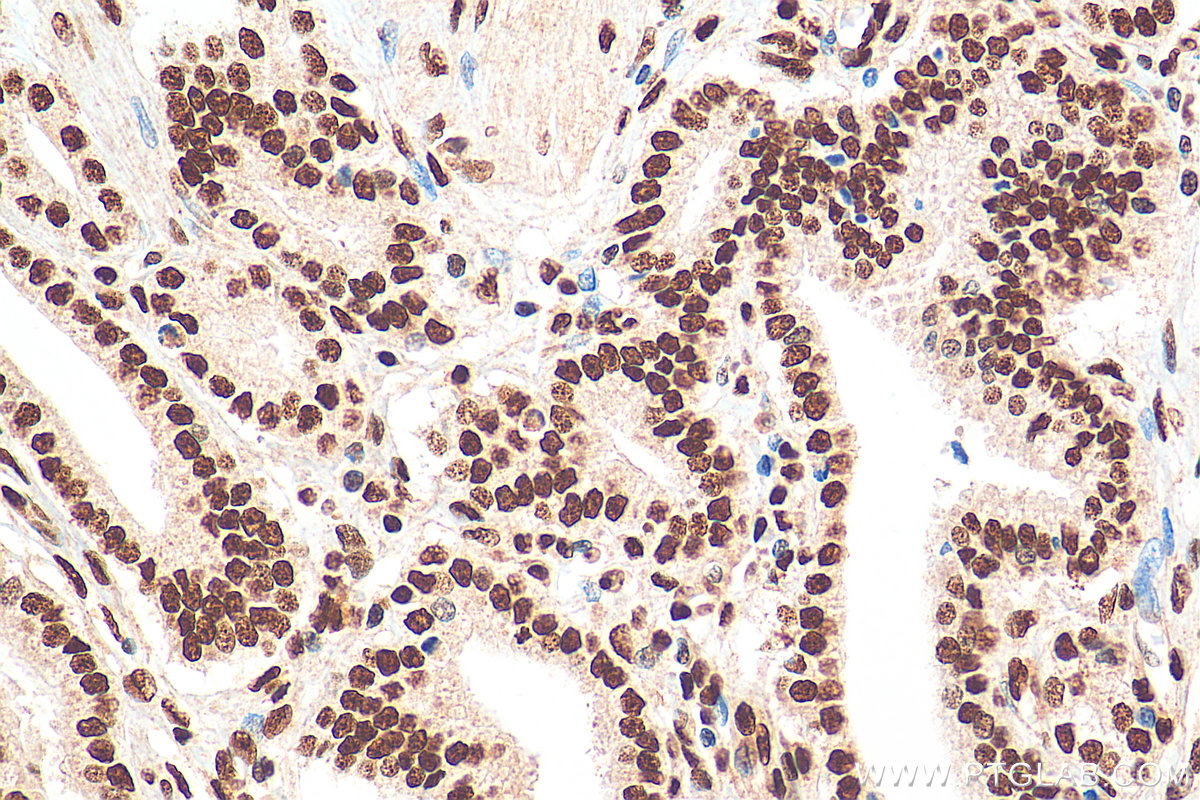

验证数据展示
经过测试的应用
| Positive WB detected in | LNCaP cells, HEK-293 cells, HeLa cells, HepG2 cells, Jurkat cells, K-562 cells, HSC-T6 cells, NIH/3T3 cells |
| Positive IHC detected in | human prostate cancer tissue, human cervical cancer tissue Note: suggested antigen retrieval with TE buffer pH 9.0; (*) Alternatively, antigen retrieval may be performed with citrate buffer pH 6.0 |
| Positive IF/ICC detected in | A431 cells |
| Positive FC (Intra) detected in | Jurkat cells, HEK-293 cells |
推荐稀释比
| 应用 | 推荐稀释比 |
|---|---|
| Western Blot (WB) | WB : 1:5000-1:50000 |
| Immunohistochemistry (IHC) | IHC : 1:1000-1:4000 |
| Immunofluorescence (IF)/ICC | IF/ICC : 1:4000-1:16000 |
| Flow Cytometry (FC) (INTRA) | FC (INTRA) : 0.20 ug per 10^6 cells in a 100 µl suspension |
| It is recommended that this reagent should be titrated in each testing system to obtain optimal results. | |
| Sample-dependent, Check data in validation data gallery. | |
产品信息
67927-1-Ig targets CREB1 in WB, IHC, IF/ICC, IP, CoIP, ELISA applications and shows reactivity with human, mouse, rat samples.
| 经测试应用 | WB, IHC, IF/ICC, ELISA Application Description |
| 文献引用应用 | WB, IF, IP, CoIP |
| 经测试反应性 | human, mouse, rat |
| 文献引用反应性 | human, mouse, rat, rabbit |
| 免疫原 |
CatNo: Ag2852 Product name: Recombinant human CREB1 protein Source: e coli.-derived, PGEX-4T Tag: GST Domain: 1-341 aa of BC010636 Sequence: MTMESGAENQQSGDAAVTEAENQQMTVQAQPQIATLAQVSMPAAHATSSAPTVTLVQLPNGQTVQVHGVIQAAQPSVIQSPQVQTVQSSCKDLKRLFSGTQISTIAESEDSQESVDSVTDSQKRREILSRRPSYRKILNDLSSDAPGVPRIEEEKSEEETSAPAITTVTVPTPIYQTSSGQYIAITQGGAIQLANNGTDGVQGLQTLTMTNAAATQPGTTILQYAQTTDGQQILVPSNQVVVQAASGDVQTYQIRTAPTSTIAPGVVMASSPALPTQPAEEAARKREVRLMKNREAARECRRKKKEYVKCLENRVAVLENQNKTLIEELKALKDLYCHKSD 种属同源性预测 |
| 宿主/亚型 | Mouse / IgG1 |
| 抗体类别 | Monoclonal |
| 产品类型 | Antibody |
| 全称 | cAMP responsive element binding protein 1 |
| 别名 | 1E11C1, cAMP-responsive element-binding protein 1, CREB, CREB 1, CREB-1 |
| 计算分子量 | 341 aa, 35 kDa |
| 观测分子量 | 43-46 kDa |
| GenBank蛋白编号 | BC010636 |
| 基因名称 | CREB1 |
| Gene ID (NCBI) | 1385 |
| RRID | AB_2918679 |
| 偶联类型 | Unconjugated |
| 形式 | Liquid |
| 纯化方式 | Protein G purification |
| UNIPROT ID | P16220 |
| 储存缓冲液 | PBS with 0.02% sodium azide and 50% glycerol, pH 7.3. |
| 储存条件 | Store at -20°C. Stable for one year after shipment. Aliquoting is unnecessary for -20oC storage. |
背景介绍
CREB1, also named as CREB, belongs to the bZIP family, containing one bZIP domain and one KID (kinase-inducible) domain. This protein binds the cAMP response element (CRE), a sequence present in many viral and cellular promoters. CREB stimulates transcription on binding to the CRE. This protein is stimulated by phosphorylation. Phosphorylation of both Ser-133 and Ser-142 in the SCN regulates the activity of CREB and participates in circadian rhythm generation. Phosphorylation of Ser-133 allows CREBBP binding. Transcription activation is enhanced by the TORC coactivators which act independently of Ser-133 phosphorylation. CREB1 is sumoylated by SUMO1. Sumoylation on Lys-304, but not on Lys-285, is required for nuclear localization of this protein. Sumoylation is enhanced under hypoxia, promoting nuclear localization and stabilization. Defects in CREB1 may be a cause of angiomatoid fibrous histiocytoma (AFH), a distinct variant of malignant fibrous histiocytoma that typically occurs in children and adolescents and is manifest by nodular subcutaneous growth. A chromosomal aberration involving CREB1 is found in a patient with angiomatoid fibrous histiocytoma. Translocation t(2;22)(q33;q12) with CREB1 generates a EWSR1/CREB1 fusion gene that is most common genetic abnormality in this tumor type. CREB1 exists some isoforms and range of calculated molecular weight of isoforms are 35-37 kDa and 25 kDa, but the modified CREB1 protein is about 43 kDa (PMID: 25883219 ).
实验方案
| Product Specific Protocols | |
|---|---|
| IF protocol for CREB1 antibody 67927-1-Ig | Download protocol |
| IHC protocol for CREB1 antibody 67927-1-Ig | Download protocol |
| WB protocol for CREB1 antibody 67927-1-Ig | Download protocol |
| Standard Protocols | |
|---|---|
| Click here to view our Standard Protocols |
发表文章
| Species | Application | Title |
|---|---|---|
Phytomedicine Arbutin ameliorated depression by inhibiting neuroinflammation and modulating intestinal flora | ||
Free Radic Biol Med Reprimo (RPRM) mediates neuronal ferroptosis via CREB-Nrf2/SCD1 pathways in radiation-induced brain injury | ||
ACS Chem Neurosci Quercitrin Rapidly Alleviated Depression-like Behaviors in Lipopolysaccharide-Treated Mice: The Involvement of PI3K/AKT/NF-κB Signaling Suppression and CREB/BDNF Signaling Restoration in the Hippocampus | ||
BMC Cancer Identification of TLN1 as a prognostic biomarker to effect cell proliferation and differentiation in acute myeloid leukemia | ||
Eur J Med Res DDX3X promotes endoplasmic reticulum protein reprogramming via interaction with ERN1 to amplify cerebral ischemia/reperfusion injury | ||
J Ethnopharmacol The total alkaloids of Berberidis Cortex alleviate type 2 diabetes mellitus by regulating gut microbiota, inflammation and liver gluconeogenesis |